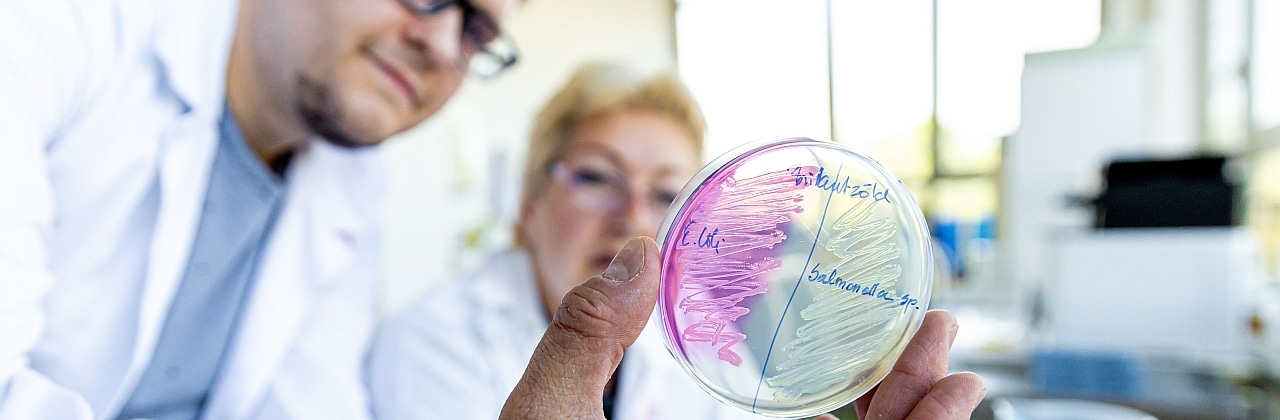

About us
Microbiology is a science dealing with the description and characterization of various microorganisms, pathogens. The Institute’s researchers are accredited PhD supervisors, they continuously welcome the students interested in microbiology during Phd courses and TDK work. In addition to research work, our colleagues perform decisive tasks in education of Hungarian, English and German-language Medical-, Dental- and ..

Useful links
Contacts
Address
1089 Budapest, Nagyvárad tér 4. X. emelet
1089 Budapest, Nagyvárad tér 4. X. emelet
Phone
+36 1 210 2930 | +36 1 210 2940
+36 1 210 2930 | +36 1 210 2940
Fax
+36 1 210 2959
+36 1 210 2959
E-mail
titkarsag.mikro@med.semmelweis-univ.hu
titkarsag.mikro@med.semmelweis-univ.hu